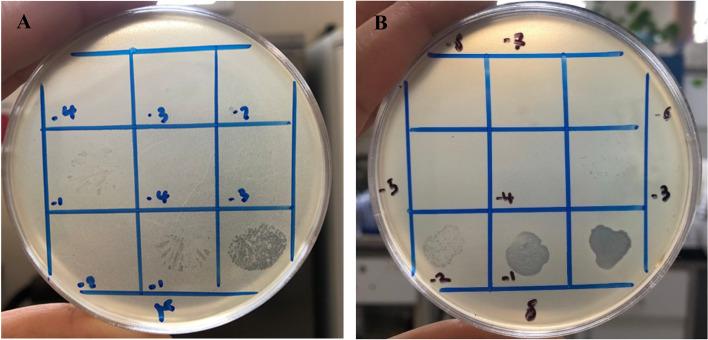
https://cdn.ncbi.nlm.nih.gov/pmc/blobs/836c/9670557/645fba902488/12917_2022_3501_Fig3_HTML.jpg

从奶牛乳腺炎中分离和评估抗多药耐药(MDR)、耐甲氧西林(MRSA)和产生物膜的金黄色葡萄球菌噬菌体的功效。
Isolation and evaluation of the efficacy of bacteriophages against multidrug-resistant (MDR), methicillin-resistant (MRSA) and biofilm-producing strains of Staphylococcus aureus recovered from bovine mastitis.
机构信息
Department of Clinical Sciences, Faculty of Veterinary Medicine, Ferdowsi University of Mashhad, P.O. Box: 9177948974, Mashhad, Khorasan Razavi Province, Iran.
Department of Pathobiology, Faculty of Veterinary Medicine, Ferdowsi University of Mashhad, Mashhad, Iran.
出版信息
BMC Vet Res. 2022 Nov 17;18(1):406. doi: 10.1186/s12917-022-03501-3.
BACKGROUND
Staphylococcus aureus (S. aureus) is one of the major causes of bovine mastitis with significant economic losses around the worldwide. The emergence of multidrug-resistant (MDR), methicillin-resistant (MRSA) and biofilm-producing strains of S. aureus challenges the treatment strategies based on the antibiotic application. Today, alternative or combinational treatment options such as bacteriophage application has received much attention. The goal of the present study was to focus on isolation and evaluation of the efficacy of bacteriophages with specific lytic activity against S. aureus strains with low cure rates (MDR, MRSA and biofilm-producing strains).
RESULTS
In the present study, two phages belonging to the Podoviridae family with specific lytic activity against S. aureus were isolated from the sewage of dairy farms and designated as Staphylococcus phage M8 and Staphylococcus phage B4. Latent period and burst size for Staphylococcus phage M8 (70 min, 72 PFU/cell) and Staphylococcus phage B4 (30 min, 447 PFU/cell) were also defined. Our results revealed the susceptibility of MDR (4/20; 20%), MRSA (4/13; 30.8%) and biofilm-producing (1/10; 10%) strains to Staphylococcus phage M8. Moreover, one biofilm-producing strain (1/10; 10%) was susceptible to Staphylococcus phage B4. Furthermore, both phages kept their lytic activity in milk. They reduced the S. aureus population by about 3 logs in cultured milk after 8 h of incubation.
CONCLUSION
In conclusion, it seems that both phages had the potential to serve as biological control agents alone or in combination with other agents such as antibiotics against infections induced by S. aureus. However, further studies are needed to investigate the efficacy of these phages in vivo.
背景
金黄色葡萄球菌(S. aureus)是引起奶牛乳腺炎的主要原因之一,给全球范围内造成了重大的经济损失。耐多药(MDR)、耐甲氧西林金黄色葡萄球菌(MRSA)和生物膜产生菌株的出现,对基于抗生素应用的治疗策略提出了挑战。如今,噬菌体应用等替代或组合治疗选择受到了广泛关注。本研究的目的是专注于分离和评估具有特定裂解活性的噬菌体对治愈率低的金黄色葡萄球菌菌株(MDR、MRSA 和生物膜产生菌株)的疗效。
结果
在本研究中,从奶牛场污水中分离到了两株属于肌尾噬菌体科、具有特定裂解活性的噬菌体,分别命名为金黄色葡萄球菌噬菌体 M8 和金黄色葡萄球菌噬菌体 B4。金黄色葡萄球菌噬菌体 M8 的潜伏期和爆发量分别为 70 分钟和 72 噬菌斑形成单位/细胞;金黄色葡萄球菌噬菌体 B4 的潜伏期和爆发量分别为 30 分钟和 447 噬菌斑形成单位/细胞。我们的研究结果表明,MDR(4/20;20%)、MRSA(4/13;30.8%)和生物膜产生菌株(1/10;10%)对金黄色葡萄球菌噬菌体 M8 敏感。此外,一株生物膜产生菌株(1/10;10%)对金黄色葡萄球菌噬菌体 B4 敏感。此外,两种噬菌体在牛奶中仍保持其裂解活性。孵育 8 小时后,它们使培养牛奶中的金黄色葡萄球菌数量减少了约 3 个对数级。
结论
总之,两种噬菌体都有可能单独或与抗生素等其他药物联合作为生物防治剂,用于治疗金黄色葡萄球菌感染。然而,还需要进一步的研究来评估这些噬菌体在体内的疗效。